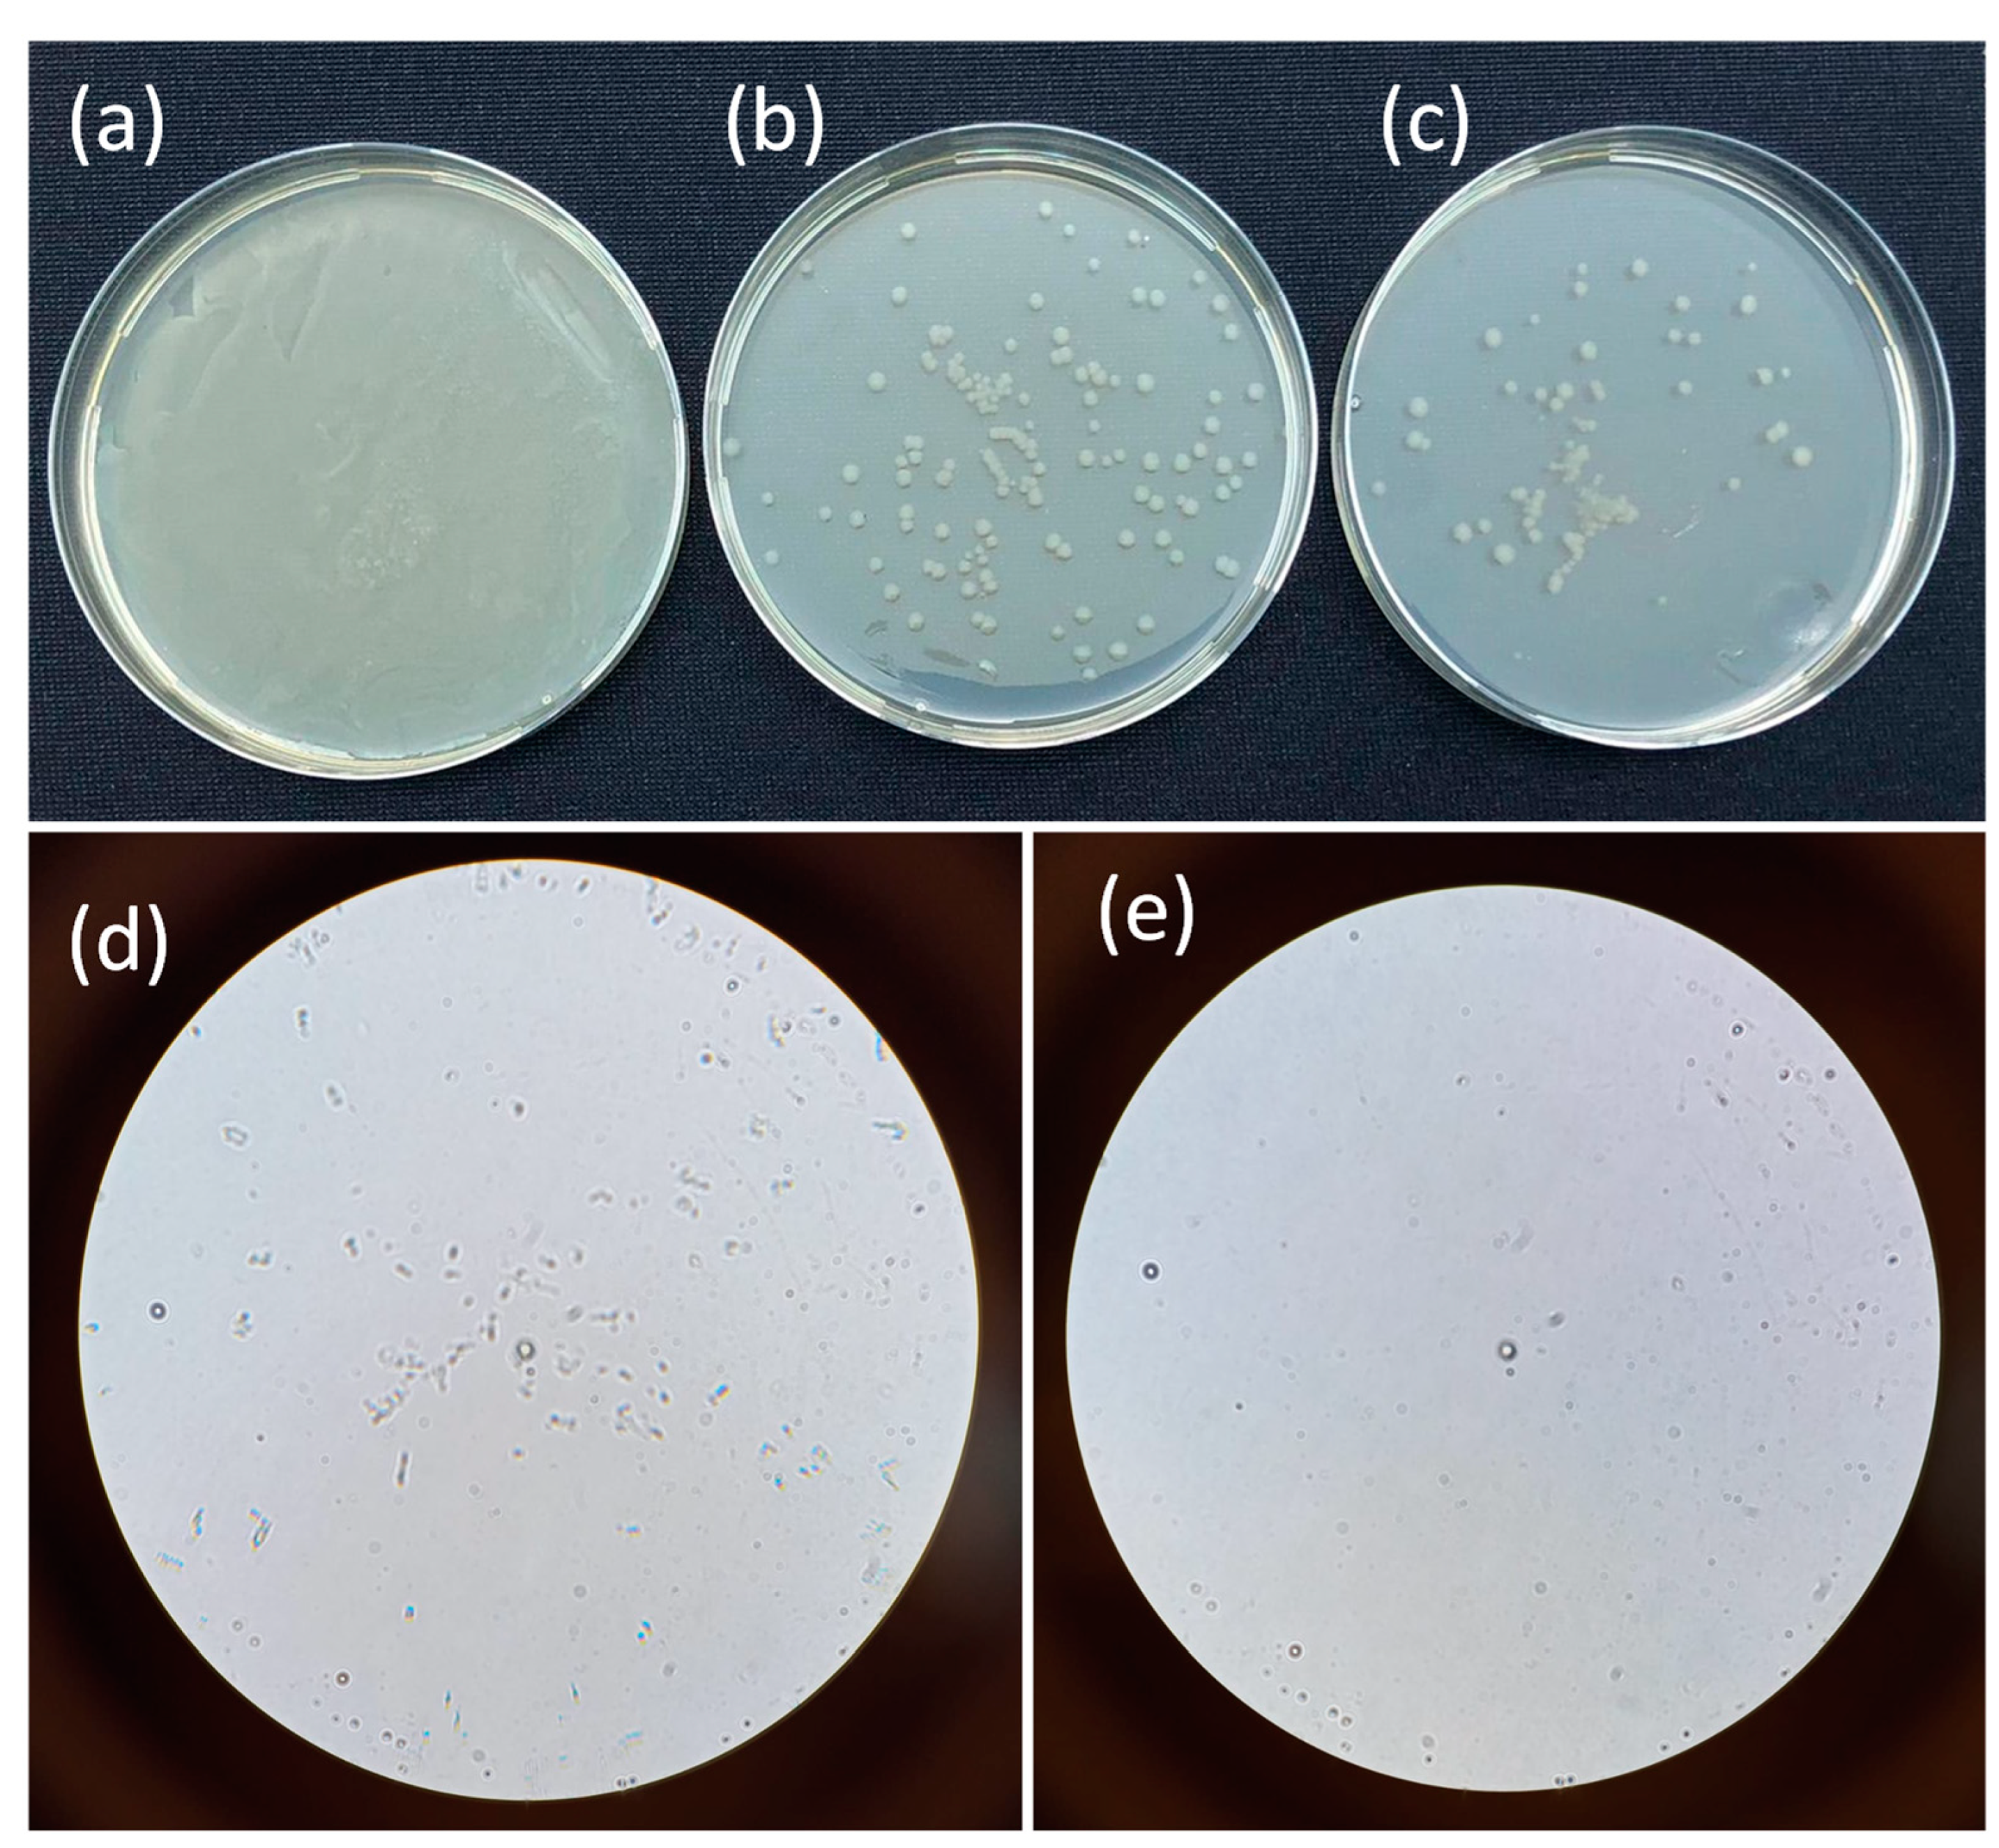

Development of ZnFeCe Layered Double Hydroxide Incorporated Thin Film Nanocomposite Membrane with Enhanced Separation Performance and Antibacterial Properties
Abstract
1. Introduction
2. Materials and Methods
2.1. Materials
2.2. Synthesis of ZnFeCe LDH
2.3. Characterization of ZnFeCe LDH
2.4. Fabrication of Membranes
2.5. Membrane Characterization
2.6. Separation
2.7. Photodegradation Studies
2.8. Antibacterial Properties
3. Results and Discussion
3.1. Characterization of ZnFeCe LDH
3.2. Characterization of TFC and TFN Membranes
3.3. Desalination Performance
3.4. Dye and Salt Separation Performance
3.5. Self-Cleaning Properties
3.6. Antibacterial Properties
4. Conclusions
Supplementary Materials
Author Contributions
Funding
Data Availability Statement
Acknowledgments
Conflicts of Interest
References
- Tzanakakis, V.A.; Paranychianakis, N.V.; Angelakis, A.N. Water Supply and Water Scarcity. Water 2020, 12, 2347. [Google Scholar] [CrossRef]
- Vatanpour, V.; Faghani, S.; Keyikoglu, R.; Khataee, A. Enhancing the permeability and antifouling properties of cellulose acetate ultrafiltration membrane by incorporation of ZnO@graphitic carbon nitride nanocomposite. Carbohydr. Polym. 2021, 256, 117413. [Google Scholar] [CrossRef] [PubMed]
- Ji, C.; Zhai, Z.; Jiang, C.; Hu, P.; Zhao, S.; Xue, S.; Yang, Z.; He, T.; Niu, Q.J. Recent advances in high-performance TFC membranes: A review of the functional interlayers. Desalination 2021, 500, 114869. [Google Scholar] [CrossRef]
- Wei, X.; Liu, Y.; Zheng, J.; Wang, X.; Xia, S.; Van der Bruggen, B. A critical review on thin-film nanocomposite membranes enabled by nanomaterials incorporated in different positions and with diverse dimensions: Performance comparison and mechanisms. J. Membr. Sci. 2022, 661, 120952. [Google Scholar] [CrossRef]
- Johnson, D.J.; Hilal, N. Nanocomposite nanofiltration membranes: State of play and recent advances. Desalination 2022, 524, 115480. [Google Scholar] [CrossRef]
- Zhao, D.L.; Japip, S.; Zhang, Y.; Weber, M.; Maletzko, C.; Chung, T.-S. Emerging thin-film nanocomposite (TFN) membranes for reverse osmosis: A review. Water Res. 2020, 173, 115557. [Google Scholar] [CrossRef] [PubMed]
- Jeong, B.-H.; Hoek, E.M.; Yan, Y.; Subramani, A.; Huang, X.; Hurwitz, G.; Ghosh, A.K.; Jawor, A. Interfacial polymerization of thin film nanocomposites: A new concept for reverse osmosis membranes. J. Membr. Sci. 2007, 294, 1–7. [Google Scholar] [CrossRef]
- Fetanat, M.; Keshtiara, M.; Keyikoglu, R.; Khataee, A.; Daiyan, R.; Razmjou, A. Machine learning for design of thin-film nanocomposite membranes. Sep. Purif. Technol. 2021, 270, 118383. [Google Scholar] [CrossRef]
- Güvensoy-Morkoyun, A.; Kürklü-Kocaoğlu, S.; Yıldırım, C.; Velioğlu, S.; Karahan, H.E.; Bae, T.-H.; Tantekin-Ersolmaz, B. Carbon nanotubes integrated into polyamide membranes by support pre-infiltration improve the desalination performance. Carbon N. Y. 2021, 185, 546–557. [Google Scholar] [CrossRef]
- Wu, T.; Prasetya, N.; Li, K. Recent advances in aluminium-based metal-organic frameworks (MOF) and its membrane applications. J. Membr. Sci. 2020, 615, 118493. [Google Scholar] [CrossRef]
- Du, Y.; Huang, L.; Wang, Y.; Yang, K.; Tang, J.; Wang, Y.; Cheng, M.; Zhang, Y.; Kipper, M.J.; Belfiore, L.A.; et al. Recent developments in graphene-based polymer composite membranes: Preparation, mass transfer mechanism, and applications. J. Appl. Polym. Sci. 2019, 136, 47761. [Google Scholar] [CrossRef]
- Kumar, R.; Basak, B.; Jeon, B.-H. Sustainable production and purification of succinic acid: A review of membrane-integrated green approach. J. Clean. Prod. 2020, 277, 123954. [Google Scholar] [CrossRef]
- Rodrigues, R.; Mierzwa, J.C.; Vecitis, C.D. Mixed matrix polysulfone/clay nanoparticles ultrafiltration membranes for water treatment. J. Water Process. Eng. 2019, 31, 100788. [Google Scholar] [CrossRef]
- Shaiju, P.; Dorian, B.-B.; Senthamaraikannan, R.; Padamati, R.B. Biodegradation of poly (butylene succinate)(PBS)/stearate modified magnesium-aluminium layered double hydroxide composites under marine conditions prepared via melt compounding. Molecules 2020, 25, 5766. [Google Scholar] [CrossRef]
- Chaillot, D.; Bennici, S.; Brendlé, J. Layered double hydroxides and LDH-derived materials in chosen environmental applications: A review. Environ. Sci. Pollut. Res. 2020, 28, 24375–24405. [Google Scholar] [CrossRef] [PubMed]
- Jia, Z.; Hao, S.; Lu, X. Exfoliated Mg–Al–Fe layered double hydroxides/polyether sulfone mixed matrix membranes for adsorption of phosphate and fluoride from aqueous solutions. J. Environ. Sci. 2018, 70, 63–73. [Google Scholar] [CrossRef] [PubMed]
- Zhao, S.; Zhu, H.; Wang, Z.; Song, P.; Ban, M.; Song, X. A loose hybrid nanofiltration membrane fabricated via chelating-assisted in-situ growth of Co/Ni LDHs for dye wastewater treatment. Chem. Eng. J. 2018, 353, 460–471. [Google Scholar] [CrossRef]
- Mutharasi, Y.; Zhang, Y.; Weber, M.; Maletzko, C.; Chung, T.-S. Novel reverse osmosis membranes incorporated with Co-Al layered double hydroxide (LDH) with enhanced performance for brackish water desalination. Desalination 2021, 498, 114740. [Google Scholar] [CrossRef]
- Azad, H.; Mohsennia, M. A novel free-standing polyvinyl butyral-polyacrylonitrile/ZnAl-layered double hydroxide nanocomposite membrane for enhanced heavy metal removal from wastewater. J. Membr. Sci. 2020, 615, 118487. [Google Scholar] [CrossRef]
- Qi, M.; Li, W.; Zheng, X.; Li, X.; Sun, Y.; Wang, Y.; Li, C.; Wang, L. Cerium and Its Oxidant-Based Nanomaterials for Antibacterial Applications: A State-of-the-Art Review. Front. Mater. 2020, 7, 213. [Google Scholar] [CrossRef]
- Chang, C.-J.; Lin, C.-Y.; Hsu, M.-H. Enhanced photocatalytic activity of Ce-doped ZnO nanorods under UV and visible light. J. Taiwan Inst. Chem. Eng. 2014, 45, 1954–1963. [Google Scholar] [CrossRef]
- Suárez-Quezada, M.; Romero-Ortiz, G.; Suárez, V.; Morales-Mendoza, G.; Lartundo-Rojas, L.; Navarro-Cerón, E.; Tzompantzi, F.; Robles, S.; Gómez, R.; Mantilla, A. Photodegradation of phenol using reconstructed Ce doped Zn/Al layered double hydroxides as photocatalysts. Catal. Today 2016, 271, 213–219. [Google Scholar] [CrossRef]
- Keyikoğlu, R.; Doğan, I.N.; Khataee, A.; Orooji, Y.; Kobya, M.; Yoon, Y. Synthesis of visible light responsive ZnCoFe layered double hydroxide towards enhanced photocatalytic activity in water treatment. Chemosphere 2022, 309, 136534. [Google Scholar] [CrossRef] [PubMed]
- Balcik, C.; Ozbey-Unal, B.; Cifcioglu-Gozuacik, B.; Keyikoglu, R.; Karagunduz, A.; Khataee, A. Fabrication of PSf nanocomposite membranes incorporated with ZnFe layered double hydroxide for separation and antifouling aspects. Sep. Purif. Technol. 2022, 285, 120354. [Google Scholar] [CrossRef]
- Xie, Z.-H.; Zhou, H.-Y.; He, C.-S.; Pan, Z.-C.; Yao, G.; Lai, B. Synthesis, application and catalytic performance of layered double hydroxide based catalysts in advanced oxidation processes for wastewater decontamination: A review. Chem. Eng. J. 2021, 414, 128713. [Google Scholar] [CrossRef]
- Zhang, Y.; Jing, S.; Liu, H. Reactivity and mechanism of bromate reduction from aqueous solution using Zn–Fe(II)–Al layered double hydroxides. Chem. Eng. J. 2015, 266, 21–27. [Google Scholar] [CrossRef]
- Thakar, M.A.; Jha, S.S.; Phasinam, K.; Manne, R.; Qureshi, Y.; Babu, V.H. X ray diffraction (XRD) analysis and evaluation of antioxidant activity of copper oxide nanoparticles synthesized from leaf extract of Cissus vitiginea. Mater. Today Proc. 2022, 51, 319–324. [Google Scholar] [CrossRef]
- Misdan, N.; Lau, W.; Ismail, A.; Matsuura, T. Formation of thin film composite nanofiltration membrane: Effect of polysulfone substrate characteristics. Desalination 2013, 329, 9–18. [Google Scholar] [CrossRef]
- Li, H.; Shi, W.; Zhang, Y.; Du, Q.; Qin, X.; Su, Y. Improved performance of poly(piperazine amide) composite nanofiltration membranes by adding aluminum hydroxide nanospheres. Sep. Purif. Technol. 2016, 166, 240–251. [Google Scholar] [CrossRef]
- Bharali, D.; Deka, R.C. Preferential adsorption of various anionic and cationic dyes from aqueous solution over ternary Cu Mg Al layered double hydroxide. Colloids Surfaces A Physicochem. Eng. Asp. 2017, 525, 64–76. [Google Scholar] [CrossRef]
- Li, C.; Li, S.; Tian, L.; Zhang, J.; Su, B.; Hu, M.Z. Covalent organic frameworks (COFs)-incorporated thin film nanocomposite (TFN) membranes for high-flux organic solvent nanofiltration (OSN). J. Membr. Sci. 2019, 572, 520–531. [Google Scholar] [CrossRef]
- Yao, Z.; Guo, H.; Yang, Z.; Qing, W.; Tang, C.Y. Preparation of nanocavity-contained thin film composite nanofiltration membranes with enhanced permeability and divalent to monovalent ion selectivity. Desalination 2018, 445, 115–122. [Google Scholar] [CrossRef]
- Abdullah, N.; Gohari, R.; Yusof, N.; Ismail, A.; Juhana, J.; Lau, W.; Matsuura, T. Polysulfone/hydrous ferric oxide ultrafiltration mixed matrix membrane: Preparation, characterization and its adsorptive removal of lead (II) from aqueous solution. Chem. Eng. J. 2015, 289, 28–37. [Google Scholar] [CrossRef]
- Meng, Z.; Zhang, Y.; Zhang, Q.; Chen, X.; Liu, L.; Komarneni, S.; Lv, F. Novel synthesis of layered double hydroxides (LDHs) from zinc hydroxide. Appl. Surf. Sci. 2017, 396, 799–803. [Google Scholar] [CrossRef]
- Bano, S.; Mahmood, A.; Kim, S.-J.; Lee, K.-H. Graphene oxide modified polyamide nanofiltration membrane with improved flux and antifouling properties. J. Mater. Chem. A Mater. 2015, 3, 2065–2071. [Google Scholar] [CrossRef]
- Tajuddin, M.H.; Yusof, N.; Abdullah, N.; Abidin, M.N.Z.; Salleh, W.N.W.; Ismail, A.F.; Matsuura, T.; Hairom, N.H.H.; Misdan, N. Incorporation of layered double hydroxide nanofillers in polyamide nanofiltration membrane for high performance of salts rejections. J. Taiwan Inst. Chem. Eng. 2019, 97, 1–11. [Google Scholar] [CrossRef]
- Dong, H.; Wu, L.; Zhang, L.; Chen, H.; Gao, C. Clay nanosheets as charged filler materials for high-performance and fouling-resistant thin film nanocomposite membranes. J. Membr. Sci. 2015, 494, 92–103. [Google Scholar] [CrossRef]
- Rezania, J.; Vatanpour, V.; Shockravi, A.; Ehsani, M. Preparation of novel carboxylated thin-film composite polyamide-polyester nanofiltration membranes with enhanced antifouling property and water flux. React. Funct. Polym. 2018, 131, 123–133. [Google Scholar] [CrossRef]
- Zeng, Y.; Wang, L.; Zhang, L.; Yu, J.Q. An acid resistant nanofiltration membrane prepared from a precursor of poly(s-triazine-amine) by interfacial polymerization. J. Membr. Sci. 2018, 546, 225–233. [Google Scholar] [CrossRef]
- Xie, Q.; Shao, W.; Zhang, S.; Hong, Z.; Wang, Q.; Zeng, B. Enhancing the performance of thin-film nanocomposite nanofiltration membranes using MAH-modified GO nanosheets. RSC Adv. 2017, 7, 54898–54910. [Google Scholar] [CrossRef]
- Li, X.; Zhao, C.; Yang, M.; Yang, B.; Hou, D.; Wang, T. Reduced graphene oxide-NH2 modified low pressure nanofiltration composite hollow fiber membranes with improved water flux and antifouling capabilities. Appl. Surf. Sci. 2017, 419, 418–428. [Google Scholar] [CrossRef]
- Xu, M.; Feng, X.; Liu, Z.; Han, X.; Zhu, J.; Wang, J.; Van der Bruggen, B.; Zhang, Y. MOF laminates functionalized polyamide self-cleaning membrane for advanced loose nanofiltration. Sep. Purif. Technol. 2021, 275, 119150. [Google Scholar] [CrossRef]
- Zong, Y.; Ma, S.; Xue, J.; Gu, J.; Wang, M. Bifunctional NiAlFe LDH-coated membrane for oil-in-water emulsion separation and photocatalytic degradation of antibiotic. Sci. Total Environ. 2021, 751, 141660. [Google Scholar] [CrossRef] [PubMed]

| Membrane | PIP (wt.%) | TMC/n-Hexane (wt./v%) | LDH Content in TMC Solution (wt./v%) |
|---|---|---|---|
| TFC | 1 | 0.10 | 0 |
| TFN 1 | 1 | 0.10 | 0.01 |
| TFN 2 | 1 | 0.10 | 0.05 |
| TFN 3 | 1 | 0.10 | 0.10 |
| TFN 4 | 1 | 0.10 | 0.20 |
Disclaimer/Publisher’s Note: The statements, opinions and data contained in all publications are solely those of the individual author(s) and contributor(s) and not of MDPI and/or the editor(s). MDPI and/or the editor(s) disclaim responsibility for any injury to people or property resulting from any ideas, methods, instructions or products referred to in the content. |
© 2023 by the authors. Licensee MDPI, Basel, Switzerland. This article is an open access article distributed under the terms and conditions of the Creative Commons Attribution (CC BY) license (https://creativecommons.org/licenses/by/4.0/).
Share and Cite
Balcik, C.; Ozbey-Unal, B.; Sahin, B.; Buse Aydın, E.; Cifcioglu-Gozuacik, B.; Keyikoglu, R.; Khataee, A. Development of ZnFeCe Layered Double Hydroxide Incorporated Thin Film Nanocomposite Membrane with Enhanced Separation Performance and Antibacterial Properties. Water 2023, 15, 264. https://doi.org/10.3390/w15020264
Balcik C, Ozbey-Unal B, Sahin B, Buse Aydın E, Cifcioglu-Gozuacik B, Keyikoglu R, Khataee A. Development of ZnFeCe Layered Double Hydroxide Incorporated Thin Film Nanocomposite Membrane with Enhanced Separation Performance and Antibacterial Properties. Water. 2023; 15(2):264. https://doi.org/10.3390/w15020264
Chicago/Turabian StyleBalcik, Cigdem, Bahar Ozbey-Unal, Busra Sahin, Ecem Buse Aydın, Bengisu Cifcioglu-Gozuacik, Ramazan Keyikoglu, and Alireza Khataee. 2023. "Development of ZnFeCe Layered Double Hydroxide Incorporated Thin Film Nanocomposite Membrane with Enhanced Separation Performance and Antibacterial Properties" Water 15, no. 2: 264. https://doi.org/10.3390/w15020264
APA StyleBalcik, C., Ozbey-Unal, B., Sahin, B., Buse Aydın, E., Cifcioglu-Gozuacik, B., Keyikoglu, R., & Khataee, A. (2023). Development of ZnFeCe Layered Double Hydroxide Incorporated Thin Film Nanocomposite Membrane with Enhanced Separation Performance and Antibacterial Properties. Water, 15(2), 264. https://doi.org/10.3390/w15020264

